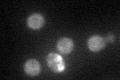
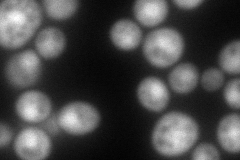
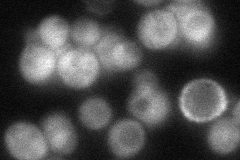
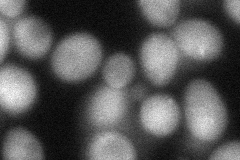
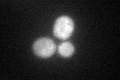
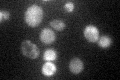

View description
Ski complex component and WD-repeat protein, mediates 3'-5' RNA degradation by the cytoplasmic exosome; also required for meiotic double-strand break recombination; null mutants have superkiller phenotype
Localization:
Intensity:
Fold change:
Significance:
-
C’ GFP library in SD
cytosol42.4 -
N' NOP1pr-GFP in SD

cytosol130.192 -
N' TEF2pr-mCherry in SD
nucleus148.984 -
N' NATIVEpr-GFP in SD
cytosol65.0741 -
N' TEF2pr-VC and Cyto-VN in SD
cytosol53.9638 -
C’ GFP library in SD+DTT
cytosol38.680.91No -
C’ GFP library in SD+H2O2

cytosol39.650.93No -
C’ GFP library in Starvation Media
cytosol67.811.59Yes -
C’ GFP library on the background of Pup2-DaMP

cytosol -
C’ GFP library on the background of CCT mutant

cytosol36.08880.851048No
